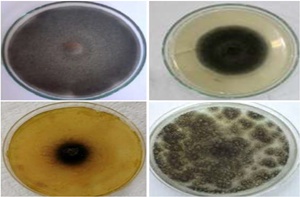

Nutrition and Food Technology
Physico-chemical and techno-functional quality of eggs of indigenous Holli hens of Benin kept under free range and confinement systems
Ulbad TOUGAN, Issaka YOUSSAO ABDOU KARIM, André THEWIS
232-240 | published: 2025-12-17
Valorization of orange peels as a source of natural antioxidants from pectin-extracted compounds
Fatma ARRARI, Imen HAMMAMI, Mohamed-Amine JABRI, Hichem SEBAI
291-296 | published: 2025-11-27
Crop Production and Environment
Effects of compost and horse manure teas on growth, yield, and quality of cucumber (Cucumis sativus L.) in Semi-Arid Nigeria
Emmanuel Abraham SHITTU, T.T BELLO, A.I ALOBO
241-246 | published: 2025-12-15
Soil-traits interactions and path analysis of growth and fertility indicators driving sugarcane (Saccharum officinarum L.) yield in the Nigerian Southern Guinea Savanna
M.S BASSEY, Emmanuel Abraham SHITTU
247-251 | published: 2025-12-15
Screening of rice genotype and evaluation of their ratooning ability in Jigawa State, Nigeria
Mustapha SUNUSI, Habu MUSA
252-256 | published: 2025-12-18
Adoption of regenerative agricultural practices among maize farmers in Katsina State, Nigeria
Bolaji Emmanuel FAWOLE, Felicia Opeyemi OLADIRAN, Aliyu ABDULKADIR
320-329 | published: 2025-12-02
Crop Protection
Phytochemical screening and assessment of various weed extracts for the management of Alternaria solani infecting Solanaceous crops
Tahseen FATIMA, Brian Gagosh NAYYAR, Iqra YOUNAS, Saba YOUNAS, Iqra RAFIQUE, Faiza KAUSAR
257-262 | published: 2025-12-15
Perception of disease transmission risks associated with domestic rats in Kinshasa households
Branham KITOKO, Andy MUYAYA, Noël MWAYAKALA, Guy MAMANU, Cyprien NATORO, Joseph MABI
263-268 | published: 2025-11-15
Feeding and contact toxicity of selected botanicals and their mixtures against Spodoptera frugiperda
Abubakar MANSUR, Iliyasu Muhammad UTONO, Sunusi MUSTAPHA, Lucius BAMAIYI, Tukur ABDULJALAL, Nasiru IBRAHIM
| published: 2025-12-03
Animal Production and Health
Prevalence and diversity of gastrointestinal parasites in primates at the JACK Sanctuary, Democratic Republic of Congo
Betty KALAMBA KAMBA, Erudit NDONGO KATENGO, Marco KANYIMBU MBAL, Macron LUKOGO NGONGO, Léonard MUTSHID NGWEJ, Didier TSHIKUNG KAMBOL MOSSES
269-274 | published: 2025-12-17
Microbiological safety of the main unconventional animal resources consumed as meat in Benin
Rogatien Agossa TOHOZIN, Ulbad Polycarpe TOUGAN, Franck HONGBETE, Rebecca A. R. ASSA Epse YAO, Modeste DJOHOUSSOU, Ibrahim IMOROU TOKO
275-281 | published: 2025-12-17
Experimental models and tools in animal research: From classical approaches to emerging trends
Dounia BKIRI, Jamal HOSSAINI HILALI
297-303 | published: 2025-11-27
Tunisian goat population: An untapped genetic resource for resilient livestock systems
Sarra CHALBI, Sonia BEDHIAF-ROMDHANI, M’Naouer DJEMALI
312-319 | published: 2025-12-02
Agricultural and Rural Economics
Post-Buharinomics agriculture in Nigeria: What next for policy, practice, and productivity?
Sanusi Mohammed SADIQ, I.P SINGH, M.M AHMAD, B.S SANI
282-290 | published: 2025-12-15
Gender-responsive approaches to carbon farming for sustainable development
SANUSI MOHAMMED SADIQ, I.P. SINGH, M.M AHMAD, B.S SANI
304-311 | published: 2025-11-27